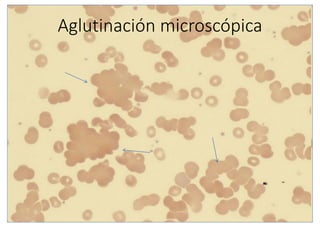
Aglutinación microscópica

El documento describe varias técnicas de inmunohematología, incluyendo la determinación de grupos sanguíneos mediante pruebas en portaobjetos, tubos y placa. Explica cómo realizar las pruebas y cómo interpretar los resultados para identificar los grupos sanguíneos A, B, AB y O. También cubre conceptos como la estructura de los anticuerpos, antígenos ABO y su herencia genética.